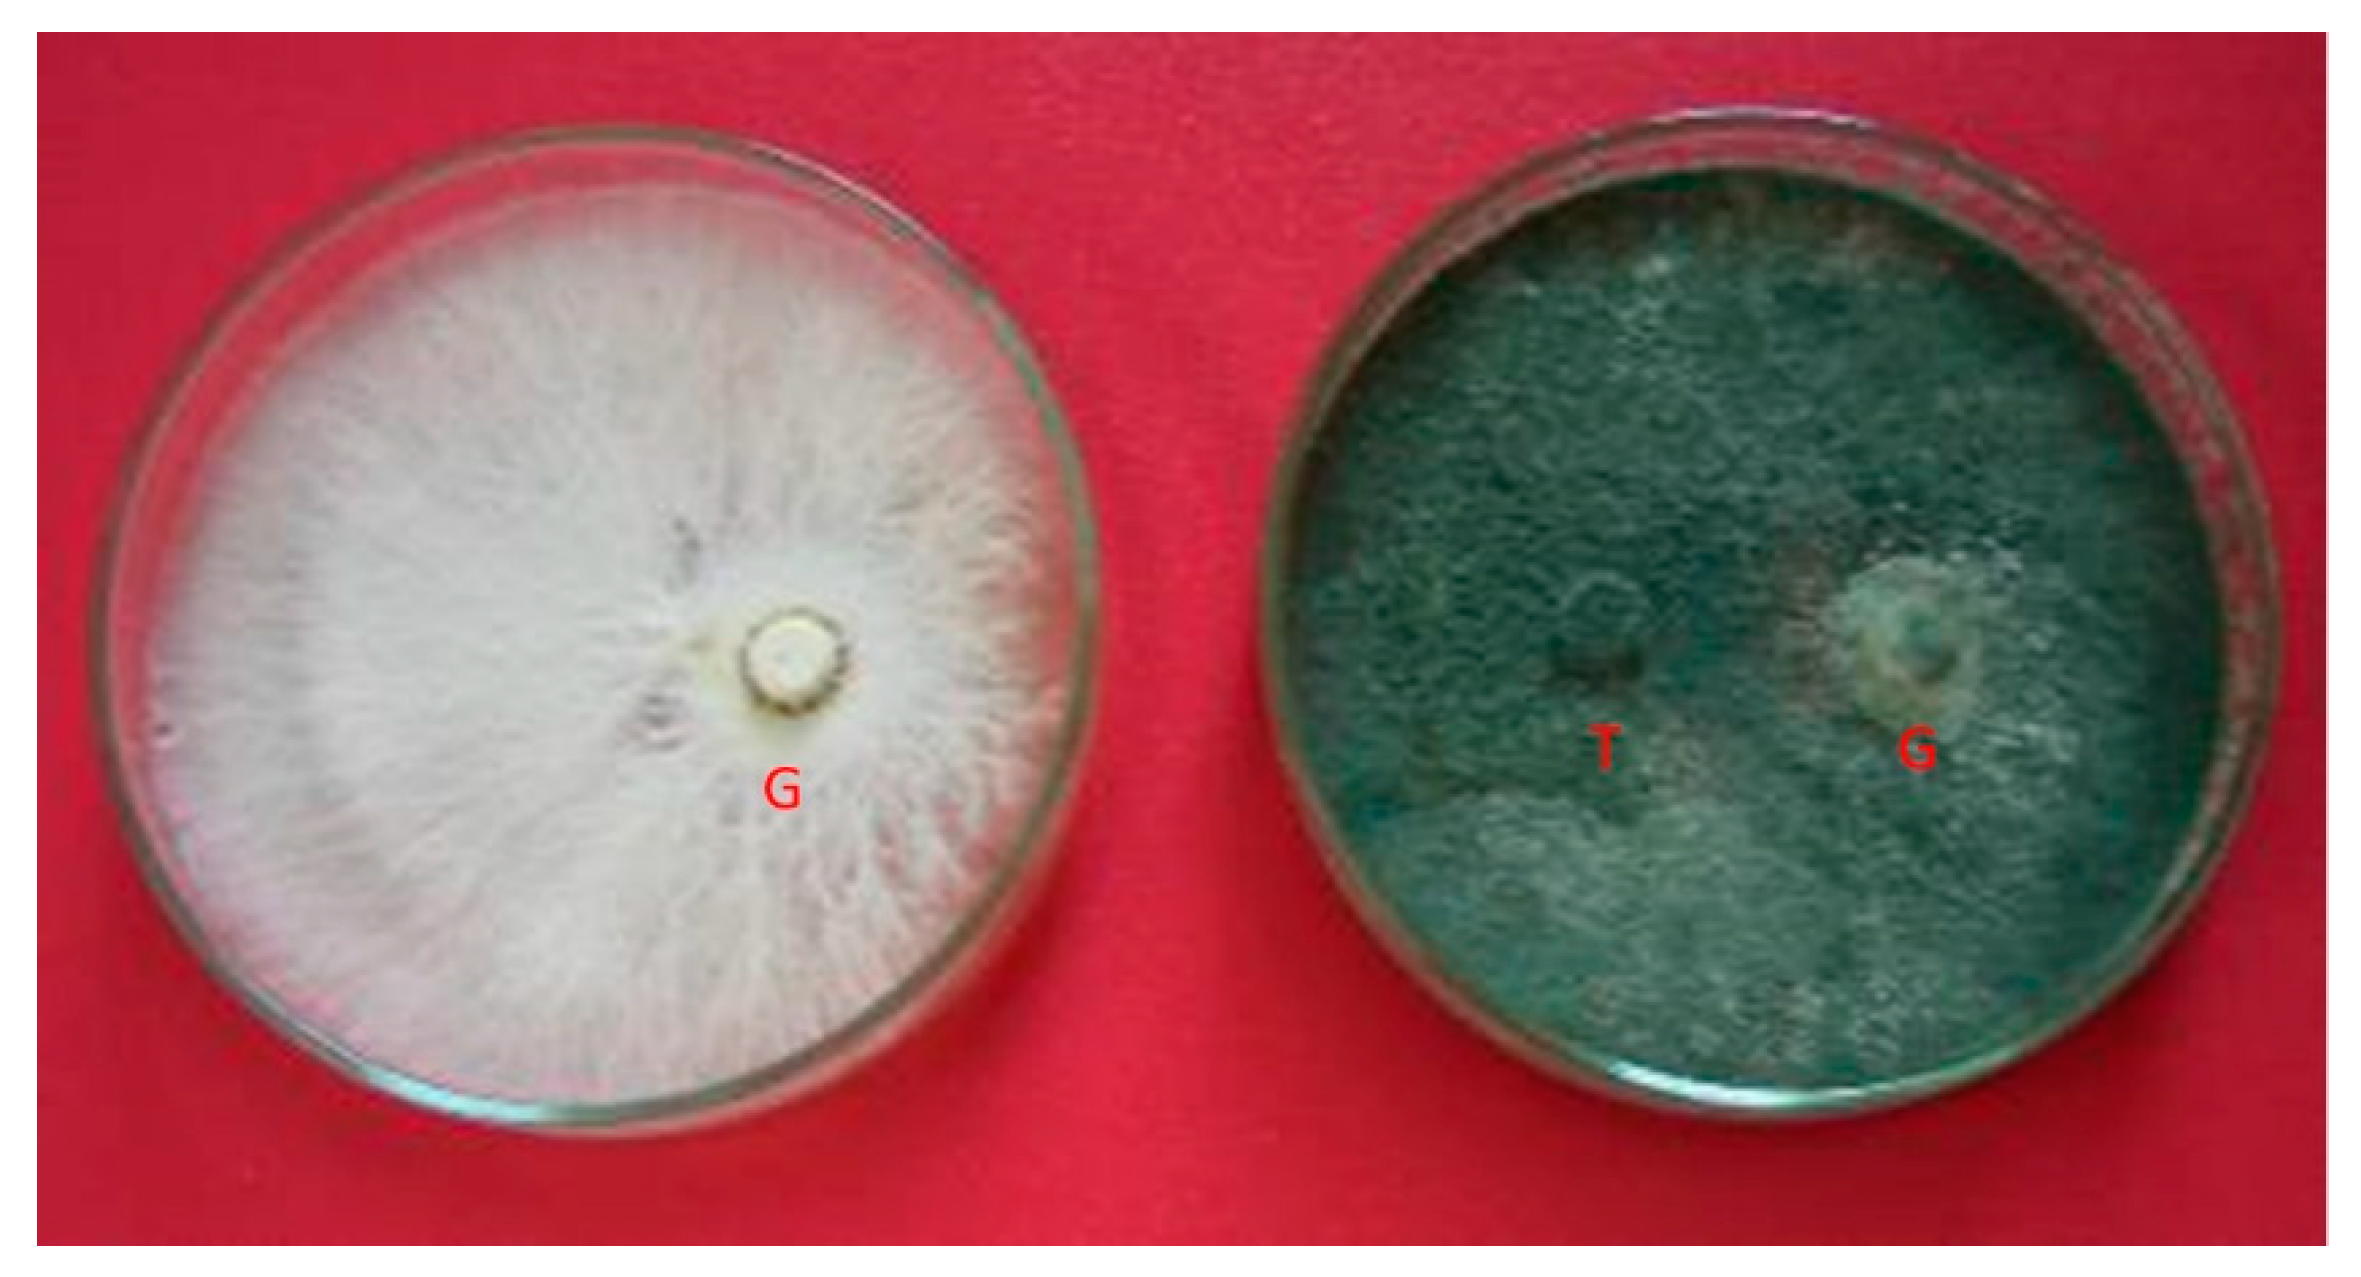
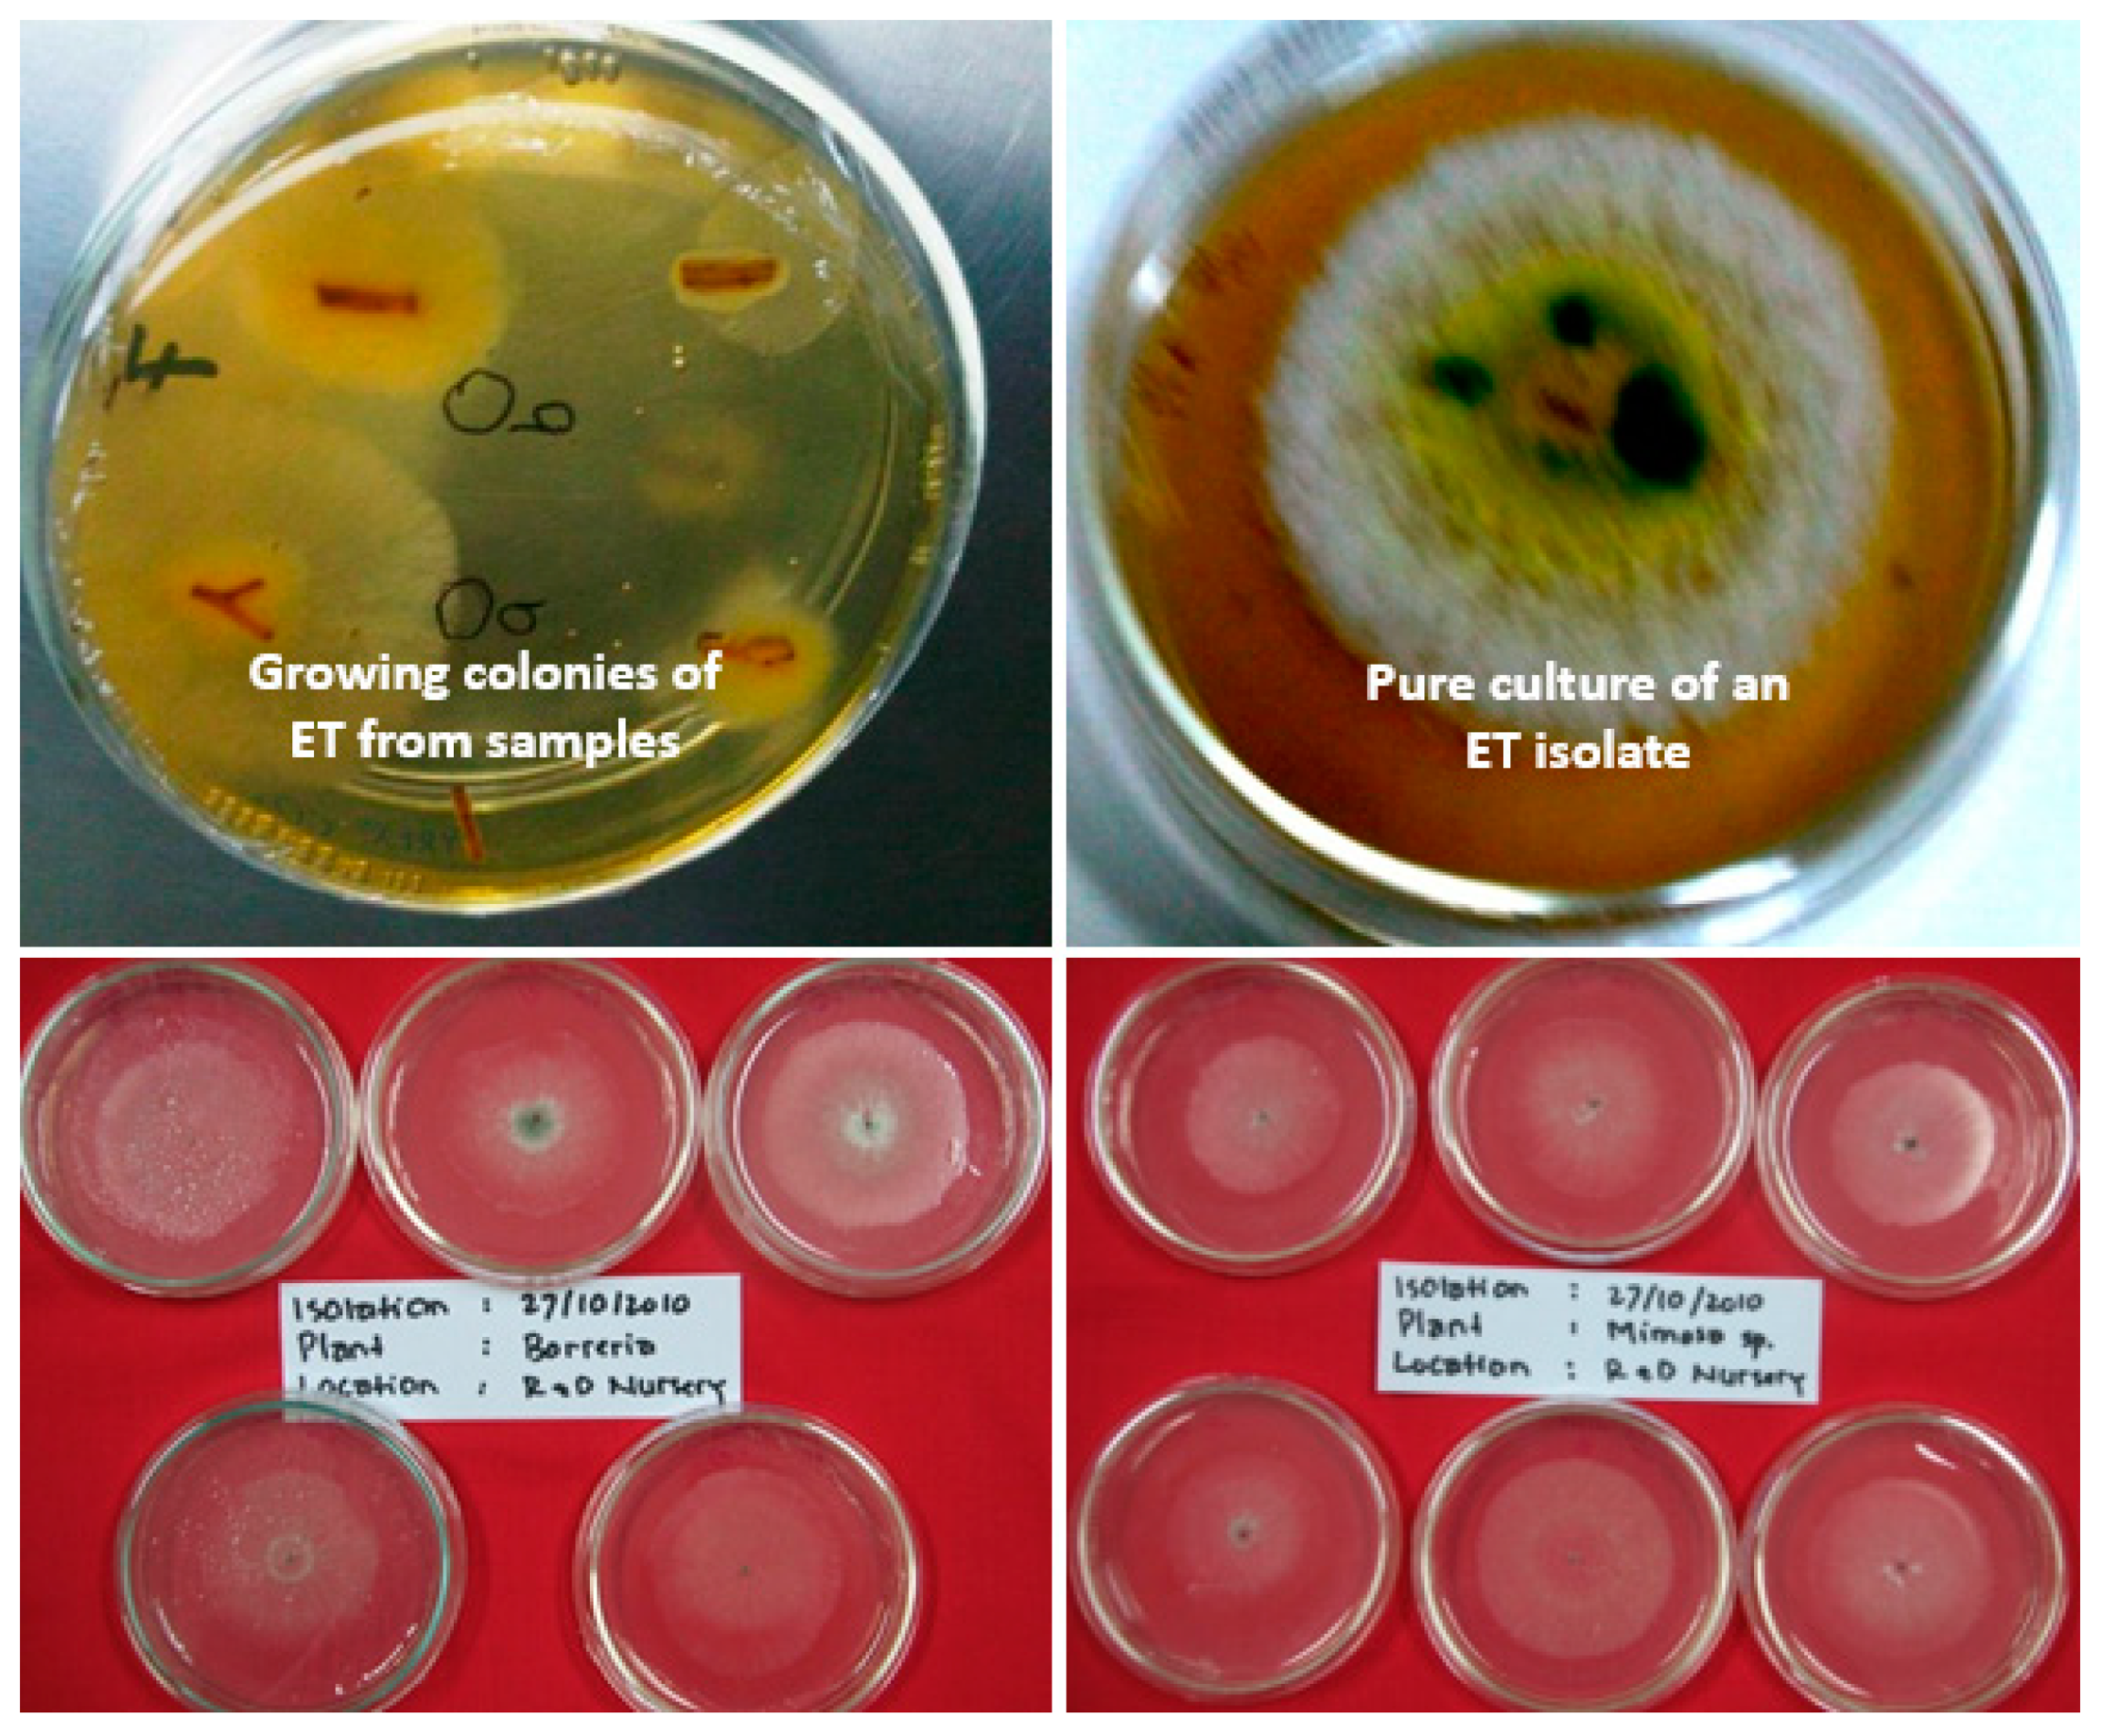
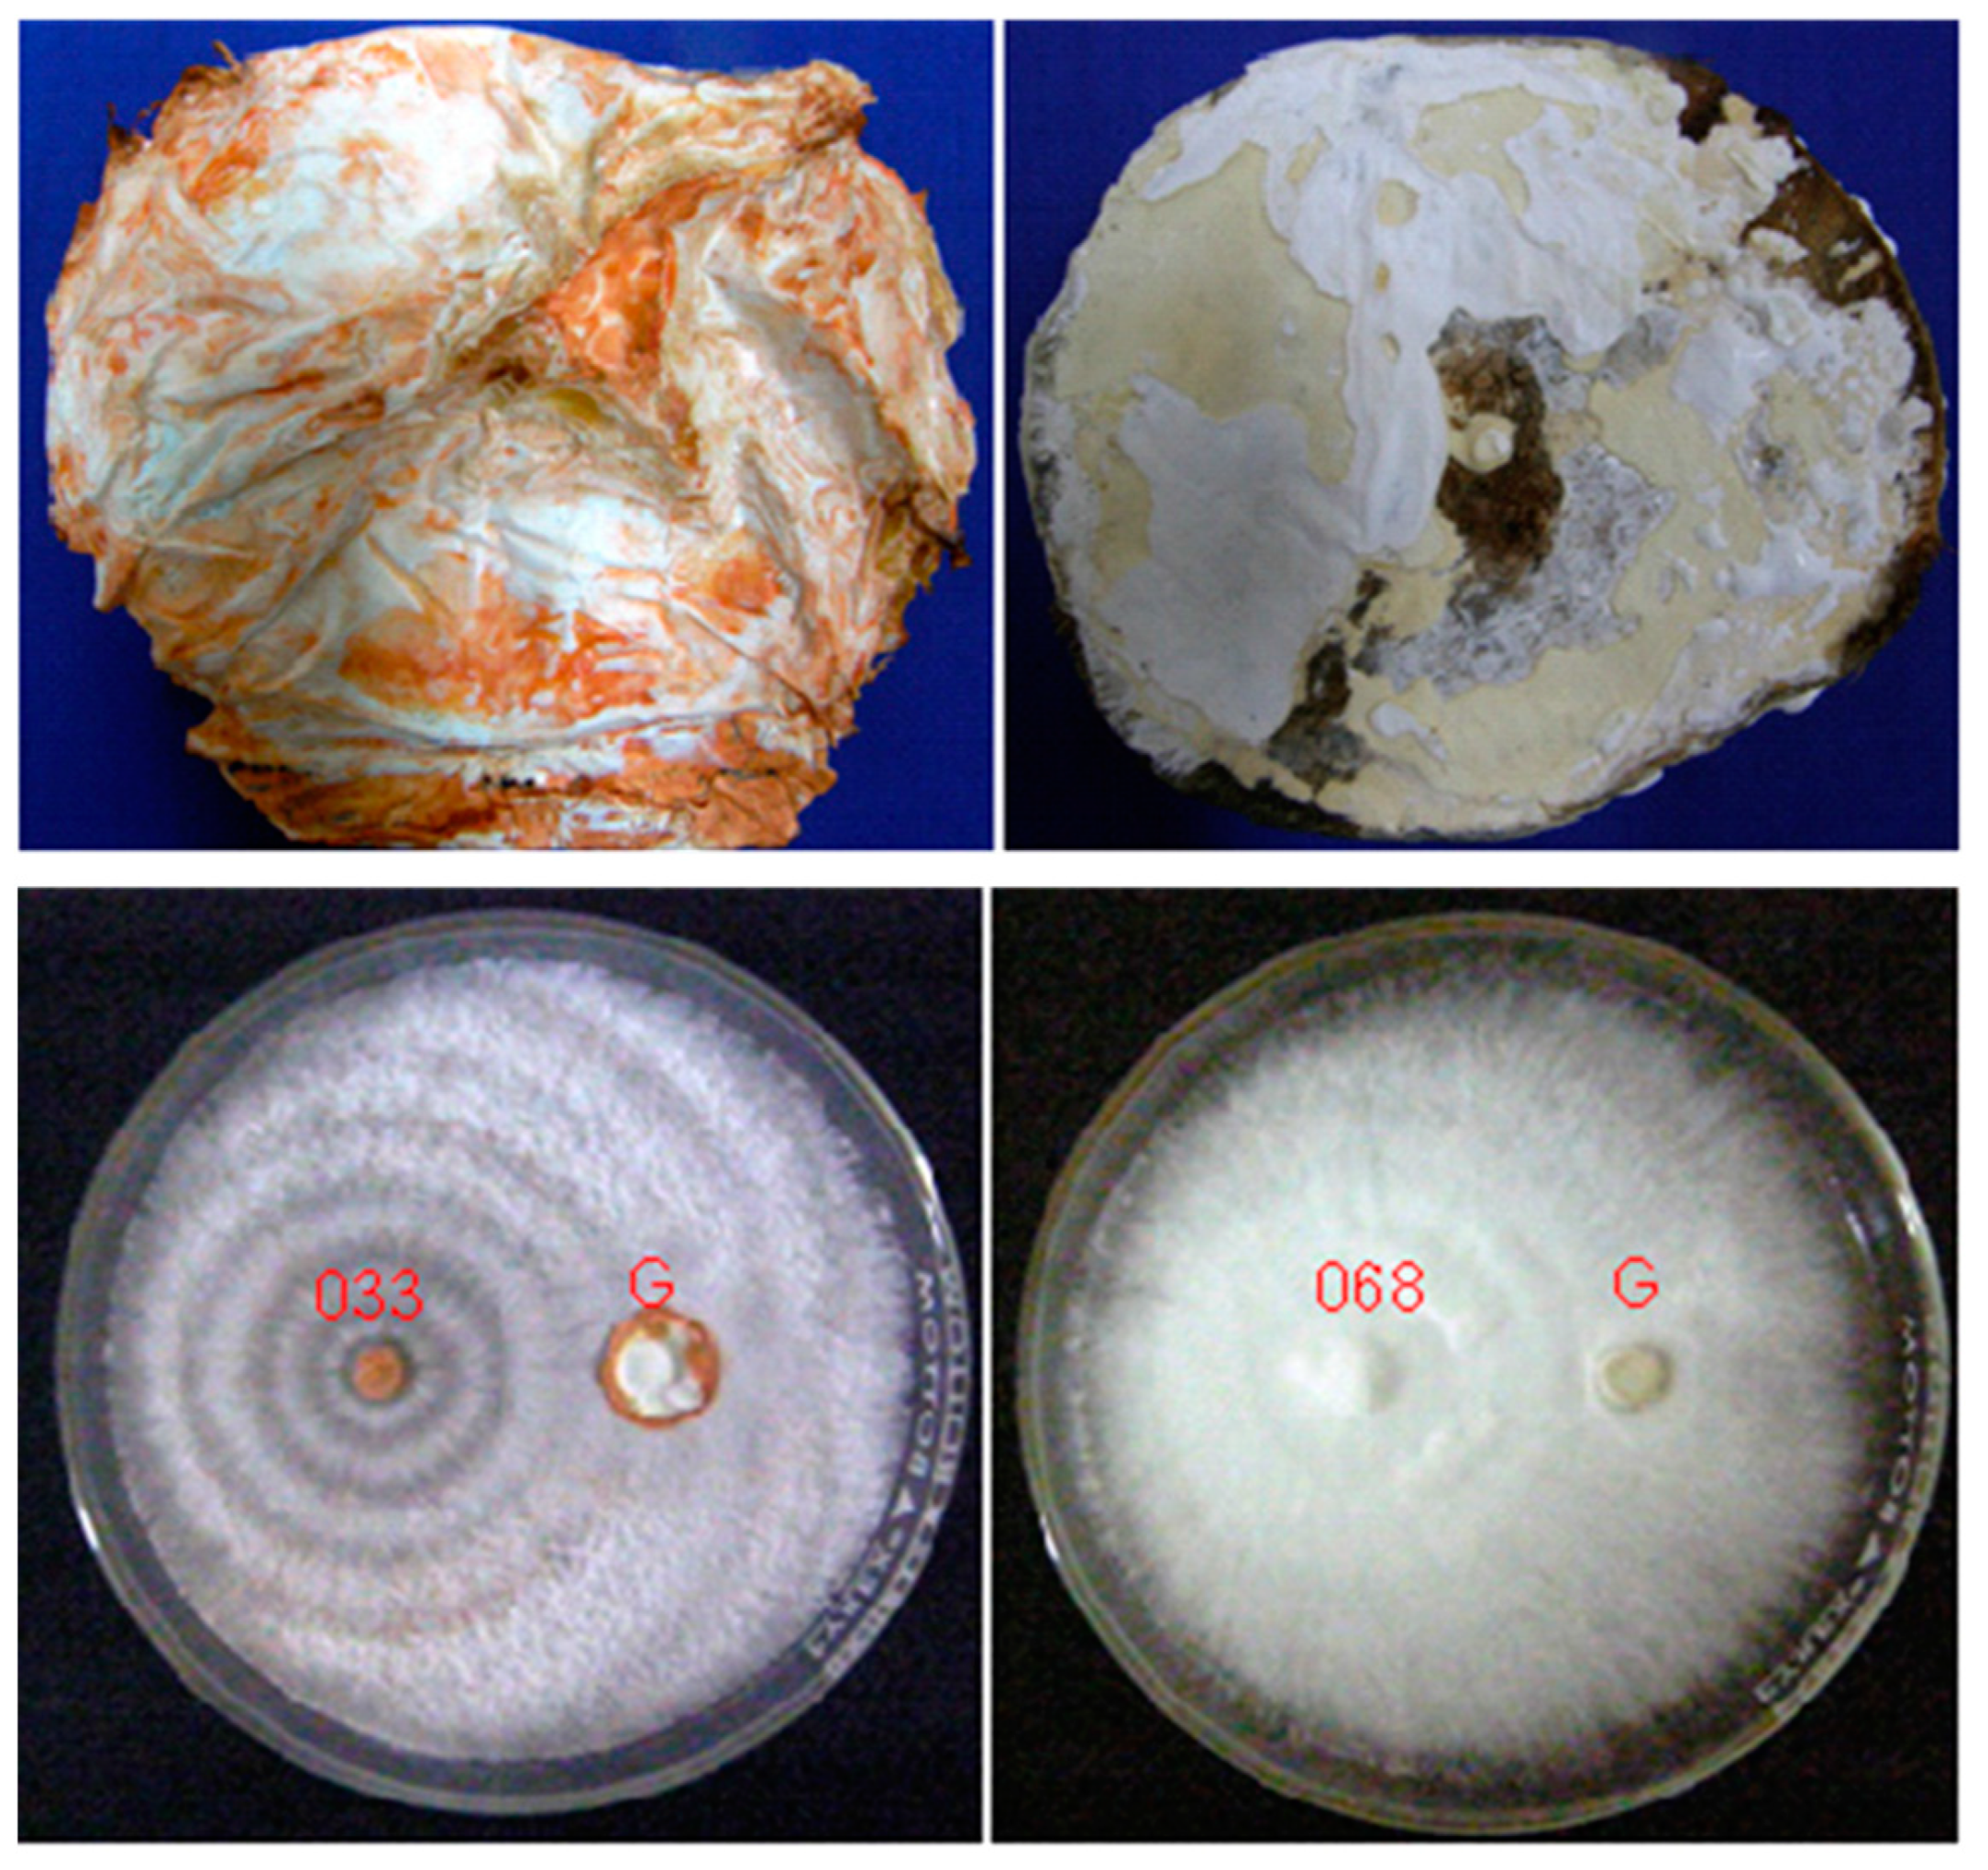

Development of Biocontrol Agents to Manage Major Diseases of Tropical Plantation Forests in Indonesia: A Review †
Abstract
:1. Introduction
2. Trichoderma and Gliocladium
3. White Rot Fungi
4. Endophytic Bacteria
5. Conclusions
Institutional Review Board Statement
Informed Consent Statement
Data Availability Statement
Conflicts of Interest
References
- Badan Pusat Statistik. Statistics of Timber Culture Establishment—2018; BPS RI: Jakarta, Indonesia, 2019; 110p.
- PPID KLHK. Available online: http://ppid.menlhk.go.id/siaran_pers/browse/1724 (accessed on 1 September 2020).
- Tjahjono, B.; Ernawati, N.M.L.; Giyanto; Gafur, A. Bacterial leaf blight on Acacia crassicarpa caused by Xanthomonas campestris in Indonesia. In Proceedings of the ISSAAS International Congress, Bali, Indonesia, 14–18 November 2010. [Google Scholar]
- Yuvika; Nasution, A.; Gafur, A. Actinomycetes isolation and in vitro screening for Xanthomonas biocontrol. J. Fitopatol. Indones. 2013, 9, 124–129. (In Indonesian) [Google Scholar] [CrossRef]
- Coetzee, M.P.A.; Golani, G.D.; Tjahjono, B.; Gafur, A.; Wingfield, B.D.; Wingfield, M.J. A single dominant Ganoderma species is responsible for root rot of Acacia mangium and Eucalyptus in Sumatra. South. For. 2011, 73, 175–180. [Google Scholar] [CrossRef]
- Glen, M.; Bougher, N.L.; Francis, A.; Nigga, S.Q.; Lee, S.S.; Irianto, R.; Barry, K.M.; Mohammed, C.L. Molecular differentiation of Ganoderma and Amouroderma species associated with root rot disease of Acacia mangium plantations in Indonesia and Malaysia. Australas. Plant Pathol. J. 2009, 38, 345–356. [Google Scholar] [CrossRef]
- Glen, M.; Yuskianti, V.; Francis, A.; Puspitasari, D.; Agustini, L.; Rimbawanto, A.; Indrayadi, H.; Gafur, A.; Mohammed, C.L. Identification of basidiomycete fungi in Indonesian hardwood plantations by DNA bar-coding. For. Pathol. 2014, 44, 496–508. [Google Scholar] [CrossRef]
- Yuskianti, V.; Glen, M.; Francis, A.; Rimbawanto, A.; Gafur, A.; Indrayadi, H.; Mohammed, C.L. Species-specific PCR for rapid identification of Ganoderma philippii and Ganoderma mastoporum from Acacia mangium and Eucalyptus pellita plantations. For. Pathol. 2014, 44, 477–485. [Google Scholar] [CrossRef]
- Gafur, A.; Tjahjono, B.; Golani, G.D. Fungal species associated with acacia plantations in Riau, Indonesia. In Proceedings of the 2007 Asian Mycological Congress, Penang, Malaysia, 2–6 December 2007. [Google Scholar]
- Lee, S.S. The current status of root diseases of Acacia mangium Wild. In Ganoderma Diseases of Perennial Crops; Flood, J., Bridge, P.D., Holderness, M., Eds.; CABI: London, UK, 2000; pp. 71–79. [Google Scholar]
- Rimbawanto, A.; Tjahjono, B.; Gafur, A. Panduan Hama dan Penyakit Akasia dan Ekaliptus; Balai Besar Penelitian Bioteknologi dan Pemuliaan Tanaman Hutan: Yogyakarta, Indonesia, 2014; 48p. [Google Scholar]
- Wingfield, M.J.; Slippers, B.; Roux, J.; Wingfield, B.D. Novel associations between pathogens; insects and tree species threaten world forests. N. Z. J. For. Sci. 2010, 40, S95–S103. [Google Scholar]
- Francis, A.; Beadle, C.; Mardai; Indrayadi, H.; Tjahjono, B.; Gafur, A.; Glen, M.; Widyatmoko, A.; Hardyanto, E.; Junarto; et al. Basidiomycete root rots of paper-pulp tree species in Indonesia—identity, biology and control. In Proceedings of the 9th International Congress of Plant Pathology, Turin, Italy, 24–29 August 2008. [Google Scholar]
- Gafur, A.; Tjahjono, B.; Golani, G.D. Pests and Diseases of Low Elevation Eucalypts: Diagnose and Control; APRIL Forestry R&D, PT RAPP: Pangkalan Kerinci, Indonesia, 2010; 40p. [Google Scholar]
- Francis, A.; Beadle, C.; Puspitasari, D.; Irianto, R.S.B.; Rimbawanto, A.; Gafur, A.; Hardyanto, E.; Junarto; Tjahjono, B.; Mardai; et al. Disease progression in plantations of Acacia mangium affected by red root rot (Ganoderma philippii). For. Pathol. 2014, 44, 447–459. [Google Scholar] [CrossRef]
- Page, D.; Glen, M.; Puspitasari, D.; Prihatini, I.; Gafur, A.; Mohammed, C. Acacia plantations in Indonesia facilitate clonal spread of the root pathogen Ganoderma philippii. Plant Pathol. 2020, 69, 685–697. [Google Scholar] [CrossRef]
- Gafur, A.; Nasution, A.; Yuliarto, M.; Wong, C.Y.; Sharma, M. A new screening method for Ganoderma philippii tolerance in tropical Acacia species. South. For. J. For. Sci. 2015, 77, 75–81. [Google Scholar] [CrossRef]
- Gafur, A.; Syaffiary, A.; Nugroho, A.; Wong, C.Y.; Sharma, M. Plant tolerance as a component of Ganoderma philippii management in Acacia mangium plantations. In Proceedings of the Genetics of Tree-Parasite Interactions Meeting, Orleans, France, 23–28 August 2015. [Google Scholar]
- Gafur, A.; Tjahjono, B.; Golani, G.D. 2011a. Options for field management of Ganoderma root rot in Acacia mangium plantation forests. In Proceedings of the 2011 IUFRO Forest Protection Joint Meeting, Colonia del Sacramento, Uruguay, 8–11 November 2011. [Google Scholar]
- Gafur, A.; Tjahjono, B.; Golani, G.D. Silvicultural options for field management of Ganoderma root rot in Acacia mangium plantation. In Proceedings of the 4th Asian Conference on Plant Pathology and the 18th Australasian Plant Pathology Conference, Darwin, Australia, 26–29 April 2011. [Google Scholar]
- Gafur, A.; Nasution, A.; Wong, C.Y.; Sharma, M. Development of biological control agents to manage Ganoderma philippii in tropical Acacia mangium plantations. In Proceedings of the Genetics of Tree-Parasite Interactions Meeting, Orleans, France, 23–28 August 2015. [Google Scholar]
- Irianto, R.S.B.; Barry, K.; Hidayati, N.; Ito, S.; Fiani, A.; Rimbawanto, A.; Mohammed, C. Incidence and spatial analysis of root rot of Acacia mangium in Indonesia. J. Trop. For. Sci. 2006, 18, 157–165. [Google Scholar]
- Militante, E.P.; Manalo, M.Q. Root rot disease of mangium (Acacia mangium Willd.) in the Philippines. In Proceedings of the 5th International Conference on Plant Protection in the Tropics, Kuala Lumpur, Malaysia, 15–18 March 1999; Sivapragasam, A., Ismail, A.A., Sidam, A.K., Cheah, U.B., Chung, G.F., Chia, T.H., Eds.; pp. 448–450. [Google Scholar]
- Mehrotra, M.D.; Pandey, P.C.; Chakrabarti, K.; Suresh, S.; Hazra, K. Root and heart rots in Acacia mangium plantations in India. Indian For. 1996, 122, 155–160. [Google Scholar]
- Bhaskaran, R. Management of the basal stem rot disease of coconut caused by Ganoderma lucidum. In Ganoderma Diseases of Perennial Crops; Flood, J., Bridge, P.D., Holderness, M., Eds.; CABI: London, UK, 2000; pp. 121–129. [Google Scholar]
- Dharmaputra, O.S.; Tjitrosomo, H.S.S.; Abadi, A.L. Antagonistic effect of four fungal isolates to Ganoderma boninense, the causal agent of basal stem rot of oil palm. Biotropia 1989, 3, 41–49. [Google Scholar]
- Soepena, H.; Purba, R.Y.; Pawirosukarto, S. A control strategy for basal stem rot (Ganoderma) on oil palm. In Ganoderma Diseases of Perennial Crops; Flood, J., Bridge, P.D., Holderness, M., Eds.; CABI: London, UK, 2000; pp. 83–88. [Google Scholar]
- Susanto, A.; Sudharto, P.S.; Purba, R.Y. Enhancing biological control of basal stem rot disease (Ganoderma boninense) in oil palm plantations. Mycopathologia 2005, 159, 153–157. [Google Scholar] [CrossRef] [PubMed]
- Widyastuti, S.M. The biological control of Ganoderma root rot by Trichoderma. In Proceedings of the Heart Rot and Root Rot in Tropical Acacia Plantations Workshop, Yogyakarta, Indonesia, 7–9 February 2006; Potter, K., Rimbawanto, A., Beadle, C., Eds.; Centre for International Research: Canberra, Australia, 2006. ACIAR Proceedings No. 124. pp. 67–74. [Google Scholar]
- Nelson, E.E.; Thies, W.G.; McWilliams, M.G. Trichoderma spp. from roots of fumigated Douglas-fir trees infected with Phellinus weirii. Mycologia 1995, 87, 639–642. [Google Scholar] [CrossRef]
- Berglund, M.; Ronnberg, J. Effectiveness of treatment of Norway spruce stumps with Phlebiopsis gigantea at different rates of coverage for the control of Heterobasidion. For. Pathol. 2004, 34, 233–243. [Google Scholar] [CrossRef]
- Hagle, S.K.; Shaw, C.G., III. Avoiding and reducing losses from Armillaria root disease. In Armillaria Root Disease, Agricultural Handbook No. 691; Shaw, C.G., III, Kile, G.A., Eds.; USDA Forest Service: Washington, DC, USA, 1991; pp. 157–174. [Google Scholar]
- Raziq, F.; Fox, R.T.V. The integrated control of Armillaria mellea 2. Field experiments. Biol. Agric. Hortic. 2006, 23, 235–249. [Google Scholar] [CrossRef]
- Hill, R. Trichoderma root endophytes enhance plant health and vigour. In Proceedings of the 12th International Trichoderma and Gliocladium Workshop, Christchurch, New Zealand, 27–30 August 2012. [Google Scholar]
- Peterson, R.R.M. Fungi and fungal toxin as weapon. Mycol. Res. 2006, 110, 1003–1010. [Google Scholar] [CrossRef] [PubMed]
- Eyles, A.; Beadle, C.; Barry, K.; Francis, A.; Glen, M.; Mohammed, C. Management of fungal root-rot pathogens in tropical Acacia mangium plantations. For. Pathol. 2008, 38, 332–355. [Google Scholar] [CrossRef]
- Hidayati, N.; Nurrohmah, S.H.; Glen, M.; Mohammed, C.L.; Gafur, A.; Prihatini, I.; Puspitasari, D.; Rimbawanto, A. Can root rot incidence be decreased by stump inoculation with oidia of Phlebiopsis sp. and Cerrena sp.? In Proceedings of the ACIAR FST/2014/068 Final Review, Yogyakarta, Indonesia, 24–25 April 2019. [Google Scholar]
- Nurrohmah, S.H.; Hidayati, N.; Glen, M.; Mohammed, C.L.; Indrayadi, H.; Gafur, A.; Oktarina, S.; Prihatini, I.; Puspitasari, D.; Rimbawanto, A. Biocontrol application (stump trials 2 and 3). In Proceedings of the ACIAR FST/2014/068 Final Review, Yogyakarta, Indonesia, 24–25 April 2019. [Google Scholar]
- Sitompul, A.; Nasution, A.; Gafur, A.; Tjahjono, B. Screening of white rot fungi as biological control agents against Ganoderma philippii. In Proceedings of the International Seminar and 12th National Congress of the Indonesian Phypathological Society, Solo, Indonesia, 3–5 December 2011. [Google Scholar]
- Tjahjono, B.; Gafur, A.; Golani, G.D. Occurrence of bacterial wilt on acacias and eucalypts in Indonesia. In Proceedings of the ISSAAS International Congress, Bali, Indonesia, 14–18 November 2010. [Google Scholar]
- Siregar, B.A.; Gafur, A.; Nuri, P.; Halimah, H.; Tjahjono, B.; Golani, G.D. First report on infection of Eucalyptus pellita seeds by Ralstonia solanacearum. In Proceedings of the 1st International Electronic Conference on Forests (IECF), Online, 15–30 November; MDPI: Basel, Switzerland, 2020. [Google Scholar]
- Siregar, B.A.; Giyanto.; Hidayat, S.H.; Siregar, I.Z.; Tjahjono, B. Epidemiology of bacterial wilt disease on Eucalyptus pellita F. Muell. IOP Conf. Ser. Earth Environ. Sci. 2020, 468, 012033. (In Indonesian) [Google Scholar] [CrossRef]

| Location | Age (Years) | Losses (%) | Reference |
|---|---|---|---|
| Indonesia | 3–5 (2nd rotation) | 3–28 | Irianto et al. [22] |
| Malaysia | 14 | up to 40 | Lee [10] |
| The Philippines | 6–10 | 10–25 | Militante and Manalo [23] |
| India | 9–14 | ~40 | Mehrotra et al. [24] |
| Root Rot Pathogen | Biocontrol Agent | Reference |
|---|---|---|
| Ganoderma lucidum | Trichoderma harzianum | Bhaskaran [25] |
| Ganoderma boninense | Trichoderma harzianum Trichoderma spp. Gliocladium viride | Dharmaputra et al. [26] Soepena et al. [27] Susanto et al. [28] |
| Ganoderma spp. | Trichoderma spp. | Widyastuti [29] |
| Phellinus weirii | Trichoderma viride | Nelson et al. [30] |
| Armillaria sp. | Trichoderma polysporum, harzianum Trichoderma sp. Trichoderma harzianum, T. viride, T. hamatum | Berglund and Ronnberg [31] Hagle and Shaw [32] Raziq and Fox [33] |
Publisher’s Note: MDPI stays neutral with regard to jurisdictional claims in published maps and institutional affiliations. |
© 2020 by the author. Licensee MDPI, Basel, Switzerland. This article is an open access article distributed under the terms and conditions of the Creative Commons Attribution (CC BY) license (https://creativecommons.org/licenses/by/4.0/).
Share and Cite
Gafur, A. Development of Biocontrol Agents to Manage Major Diseases of Tropical Plantation Forests in Indonesia: A Review. Environ. Sci. Proc. 2021, 3, 11. https://doi.org/10.3390/IECF2020-07907
Gafur A. Development of Biocontrol Agents to Manage Major Diseases of Tropical Plantation Forests in Indonesia: A Review. Environmental Sciences Proceedings. 2021; 3(1):11. https://doi.org/10.3390/IECF2020-07907
Chicago/Turabian StyleGafur, Abdul. 2021. "Development of Biocontrol Agents to Manage Major Diseases of Tropical Plantation Forests in Indonesia: A Review" Environmental Sciences Proceedings 3, no. 1: 11. https://doi.org/10.3390/IECF2020-07907
APA StyleGafur, A. (2021). Development of Biocontrol Agents to Manage Major Diseases of Tropical Plantation Forests in Indonesia: A Review. Environmental Sciences Proceedings, 3(1), 11. https://doi.org/10.3390/IECF2020-07907
